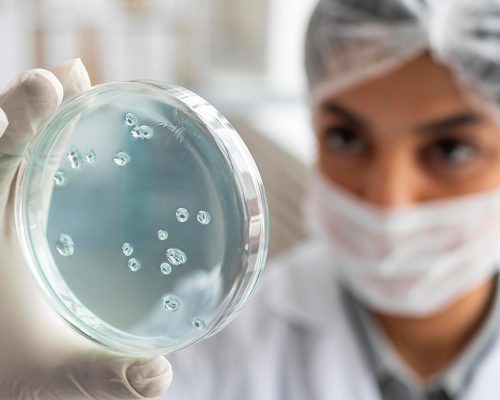

Investigador Principal: Dr. Felipe Meyer.

La investigación se ha centrado al estudio de las condiciones laborales tanto del sector minero como forestal. Es especio en conocer las características de las personas que trabajan en esos sectores, su evolución y cuáles son las demandas del trabajo que estos sectores presentan